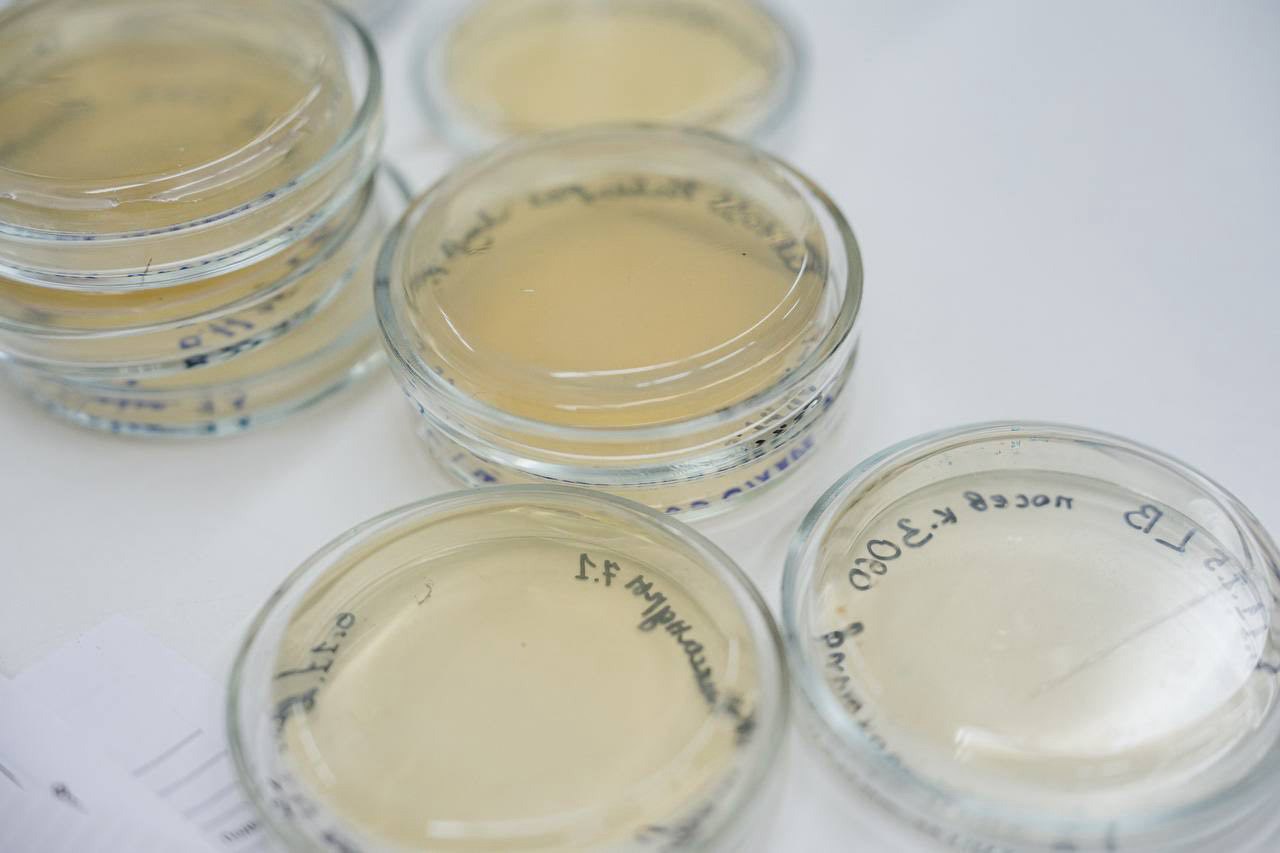
В школе «Перспектива» в Томске открыли новое пространство, где школьники будут изучать мир грибов В школе «Перспектива» в Томске открыли новое пространство, где школьники будут изучать мир грибов

В школе «Перспектива» в Томске открыли новое пространство, где школьники будут изучать мир грибов
Теперь ребята смогут проводить эксперименты по выращиванию грибов, изучать их строение и даже создавать чистые культуры. Все это стало возможным благодаря проекту «Томская научная школа микологии», который победил в грантовом конкурсе «Родные города» — программе социальных инвестиций «Газпром нефти», реализуемой при поддержке «Газпромнефть-Востока».
Теперь у юных томичей есть возможность почувствовать себя настоящими биотехнологами, выбрать собственную тему исследования и работать под руководством учителей и ученых вузов!